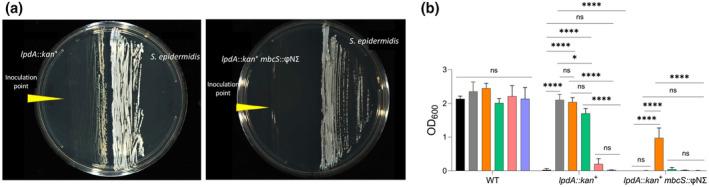

金黄色葡萄球菌中的酰基辅酶 A 合成酶 MbcS 支持支链脂肪酸的合成,其前体为羧酸和醛。
In Staphylococcus aureus, the acyl-CoA synthetase MbcS supports branched-chain fatty acid synthesis from carboxylic acid and aldehyde precursors.
机构信息
Department of Biology, Georgetown University, Washington, District of Columbia, USA.
出版信息
Mol Microbiol. 2024 May;121(5):865-881. doi: 10.1111/mmi.15237. Epub 2024 Feb 16.
In the human pathogen Staphylococcus aureus, branched-chain fatty acids (BCFAs) are the most abundant fatty acids in membrane phospholipids. Strains deficient for BCFAs synthesis experience auxotrophy in laboratory culture and attenuated virulence during infection. Furthermore, the membrane of S. aureus is among the main targets for antibiotic therapy. Therefore, determining the mechanisms involved in BCFAs synthesis is critical to manage S. aureus infections. Here, we report that the overexpression of SAUSA300_2542 (annotated to encode an acyl-CoA synthetase) restores BCFAs synthesis in strains lacking the canonical biosynthetic pathway catalyzed by the branched-chain α-keto acid dehydrogenase (BKDH) complex. We demonstrate that the acyl-CoA synthetase activity of MbcS activates branched-chain carboxylic acids (BCCAs), and is required by S. aureus to utilize the isoleucine derivative 2-methylbutyraldehyde to restore BCFAs synthesis in S. aureus. Based on the ability of some staphylococci to convert branched-chain aldehydes into their respective BCCAs and our findings demonstrating that branched-chain aldehydes are in fact BCFAs precursors, we propose that MbcS promotes the scavenging of exogenous BCCAs and mediates BCFA synthesis via a de novo alternative pathway.
在人类病原体金黄色葡萄球菌中,支链脂肪酸(BCFAs)是膜磷脂中最丰富的脂肪酸。缺乏支链脂肪酸合成的菌株在实验室培养中经历营养缺陷,在感染过程中毒力减弱。此外,金黄色葡萄球菌的膜是抗生素治疗的主要靶点之一。因此,确定参与支链脂肪酸合成的机制对于管理金黄色葡萄球菌感染至关重要。在这里,我们报告了 SAUSA300_2542 的过表达(注释为编码酰基辅酶 A 合成酶)恢复了缺乏由支链α-酮酸脱氢酶(BKDH)复合物催化的典型生物合成途径的菌株中的支链脂肪酸(BCFA)合成。我们证明了 MbcS 的酰基辅酶 A 合成酶活性激活了支链羧酸(BCCA),并且金黄色葡萄球菌需要它来利用异亮氨酸衍生物 2-甲基丁醛来恢复金黄色葡萄球菌中的支链脂肪酸(BCFA)合成。基于一些葡萄球菌将支链醛转化为其相应的 BCCA 的能力,以及我们的发现表明支链醛实际上是 BCFA 的前体,我们提出 MbcS 促进了外源 BCCA 的清除,并通过从头替代途径介导了 BCFA 合成。